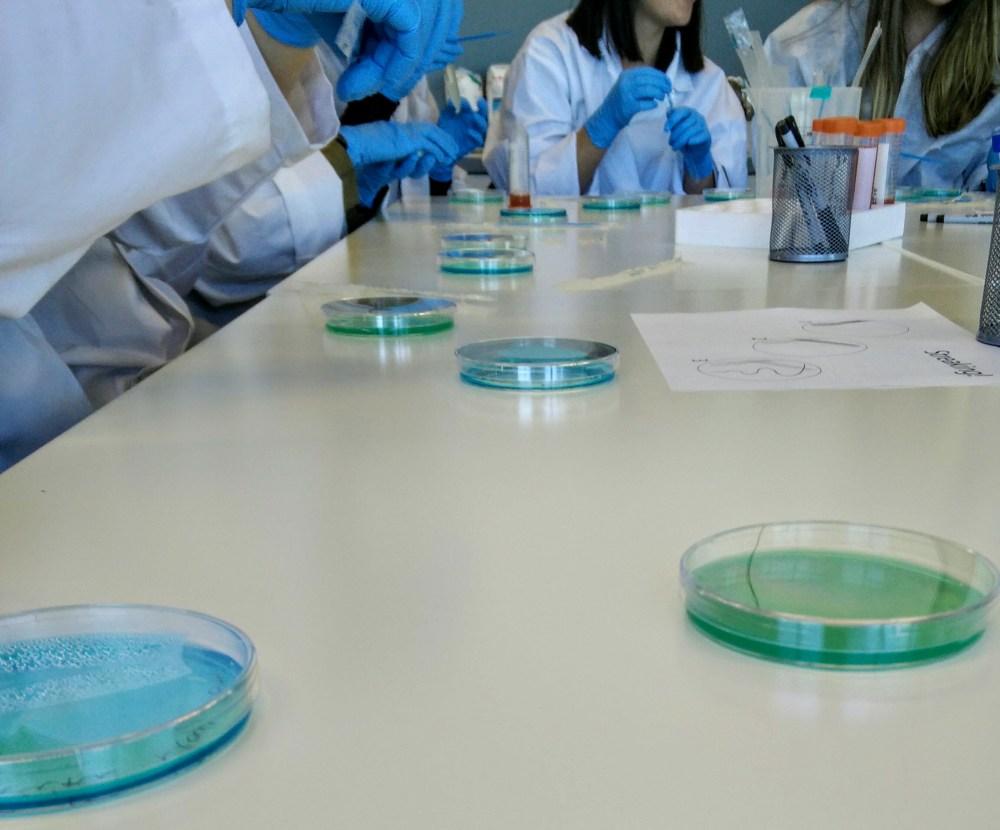
IMG_20170516_141029

Researcher: Maya Hey, PhD student in Communication Studies
Project Scope:
This project takes up everyday ferments such as yogurt and kombucha and explores their microbial profile in a laboratory setting. By demystifying the space and its concomitant skill set, this project aims to bridge the mundanity of food with the exclusivity of research labs.

This project operationalizes these objectives through workshops, engaging with a wide variety of audiences. Participants make microbes visible to the human eye by propagating microbial populations exponentially, learning how to work with petri plates, loops, and nutrient agar. Workshops allow participants to work directly with microbes from everyday, store-bought comestibles, and to work through their own preconceived notions about how microbial life (in)forms their own lives. Additionally, these workshops enable conversations about the ambient, what constitutes contamination, and how microbes factor into the everyday.
Activities / Publications:
- What’s Really in Your Yogurt?, Science Odyssey children’s workshop
- Simone de Beauvoir Institute’s SUMMER INSTITUTE, Making Invisible Bodies (Microbes) Literally Visible lecture and workshop

